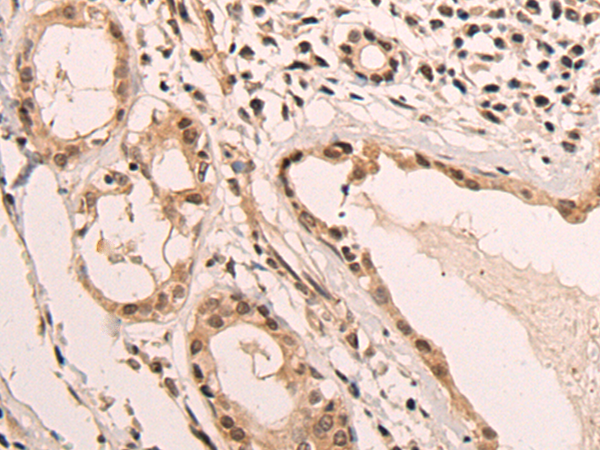
一抗

|
Background: |
EMC10, also known as C19orf63, C19orf63 is a 262 amino acid protein that exists as two alternatively isoforms and are encoded by a gene located on human chromosome 19. Chromosome 19 consists of approximately 63 million bases and makes up over 2% of human genomic DNA. Chromosome 19 includes a diversity of interesting genes and is recognized for having the greatest gene density of the human chromosomes. It is the genetic home for a number of immunoglobulin superfamily members including the killer cell and leukocyte Ig-like receptors, a number of ICAMs, the CEACAM and PSG family, and Fcα receptors. Key genes for eye color and hair color also map to chromosome 19. Peutz-Jeghers syndrome, spinocerebellar ataxia type 6, the stroke disorder CADASIL, hypercholesterolemia and insulin-dependent diabetes have been linked to chromosome 19. Translocations with chromosome 19 and chromosome 14 can be seen in some lymphoproliferative disorders and typically involve the proto-oncogene BCL3. |
|
Applications: |
ELISA, WB, IHC |
|
Name of antibody: |
EMC10 |
|
Immunogen: |
Synthetic peptide of human EMC10 |
|
Full name: |
ER membrane protein complex subunit 10 |
|
Synonyms: |
HSM1; HSS1; C19orf63 |
|
SwissProt: |
Q5UCC4 |
|
ELISA Recommended dilution: |
5000-10000 |
|
IHC positive control: |
Human esophagus cancer and human lung cancer |
|
IHC Recommend dilution: |
30-150 |
|
WB Predicted band size: |
27 kDa |
|
WB Positive control: |
Jurkat,PC-3 and A549 cell lysates |
|
WB Recommended dilution: |
200-1000 |



 購物車
購物車 幫助
幫助
 021-54845833/15800441009
021-54845833/15800441009